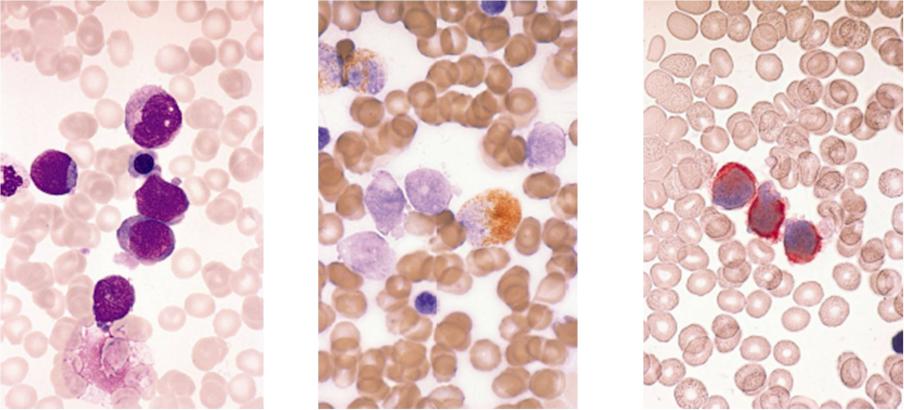

Материал: клинический+анализ+крови+3
Острый миелоидный лейкоз М7
(мегакариобластный)
Азур-эозин. |
Миелопероксидаза, |
Иммуноцитохимическое |
Бласты выглядят |
в мегакариобластах |
исследование. CD 41 |
как лимфобласты. |
отрицательна. |
рецептор тромбоцитов. |
|
|
Реакция положительна. |

Эритремия (полицитемия)
Анализ крови
Трепанобиоптат подвздошной кости: уменьшено количество жира, обилие мегакариоцитов (показаны стрелками)

Хронический миелолейкоз (ХМЛ)
Гемоглобин, г/л |
138 |
|
|
|
|
Эритроциты, х1012/л |
4,2 |
|
Цветовой показатель |
1,0 |
|
|
|
|
Ретикулоциты, % |
1,1 |
|
|
|
|
Лейкоциты, 109/л |
56,0 |
|
Миелобласты, % |
2 |
|
|
|
|
Промиелоциты, % |
4 |
|
|
|
|
Миелоциты, % |
9 |
|
|
|
|
Метамиелоциты, % |
7 |
|
|
|
|
Палочкоядерные, % |
21 |
|
|
|
|
Сегментоядерные, % |
34 |
|
|
|
|
Эозинофилы, % |
6 |
|
|
|
|
Базофилы, % |
3 |
|
|
|
|
Пролимфоциты , % |
|
|
|
|
|
Лимфоциты, % |
12 |
|
|
|
|
Моноциты, % |
2 |
|
|
|
|
Тромбоциты, 109/л |
300,0 |
|
СОЭ, мм/час |
6 |
|
|
|
Дополнительные сведения: в конце мазка много крупных агрегатов тромбоцитов.
Мазок крови
Срез с трепанобиоптата, реакция на нафтол-AS-D-хлорацетатэстеразу (окрашиваются нейтрофилы)

Хронический миелолейкоз, бластный криз
Гемоглобин, г/л |
66 |
|
|
|
|
Эритроциты, х1012/л |
2,1 |
|
Цветовой показатель |
0,94 |
|
|
|
|
Ретикулоциты, % |
0,1 |
|
|
|
|
Лейкоциты, 109/л |
26,0 |
|
Миелобласты, % |
72 |
|
|
|
|
Промиелоциты, % |
4 |
|
|
|
|
Миелоциты, % |
|
|
|
|
|
Метамиелоциты, % |
|
|
|
|
|
Палочкоядерные, % |
5 |
|
|
|
|
Сегментоядерные, % |
17 |
|
|
|
|
Эозинофилы, % |
|
|
|
|
|
Базофилы, % |
|
|
|
|
|
Пролимфоциты , % |
|
|
|
|
|
Лимфоциты, % |
1 |
|
|
|
|
Моноциты, % |
|
|
|
|
|
Тромбоциты, 109/л |
30,0 |
|
СОЭ, мм/час |
56 |
|
|
|
Дополнительные сведения: в 96% бластов положительна реакция на пероксидазу.
Мазок крови, миелобласты, один сегментоядерный нейтрофил.
Мазок костного мозга другого пациента, мегакариобласты, микроформы мегакариоцитов и агрегаты тромбоцитов.
Мегакариобластный криз.

Бактериальное воспаление
Гемоглобин, г/л |
105 |
|
|
Эритроциты, х1012/л |
3,94 |
Цветовой показатель |
0,8 |
|
|
Ретикулоциты, % |
0,9 |
|
|
Лейкоциты, 109/л |
12,3 |
Промиелоциты, % |
|
|
|
Миелоциты, % |
|
|
|
Метамиелоциты, % |
2 |
|
|
Палочкоядерные |
10 |
|
|
Сегментоядерные |
72 |
|
|
Эозинофилы |
0 |
|
|
Базофилы, % |
0 |
|
|
Лимфобласты |
|
|
|
Лимфоциты |
13 |
|
|
Моноциты, % |
3 |
|
|
Тромбоциты, 109/л |
368 |
СОЭ, мм/час |
36 |
|
|
Дополнительные сведения: токсогенная зернистость нейтрофилов ++
У больного правосторонняя нижнедолевая пневмония.